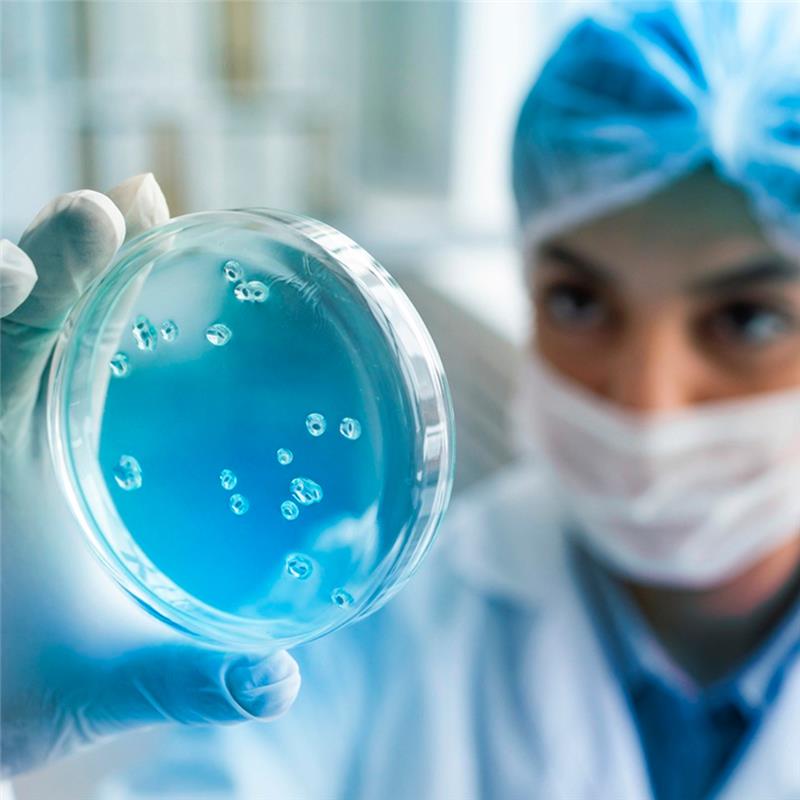
healthcare1

Digital Healthcare Solutions
Empowering Healthcare with Digital Transformation Solutions
As a trusted digital transformation partner for over two decades, we empower healthcare organizations with next-gen digital solutions designed to enhance patient care, optimize operations, and ensure regulatory compliance. Our future-ready healthcare technology solutions help providers, payers, ISVs, and medical device manufacturers seamlessly integrate digital transformation into their business strategy, ensuring sustainable growth and innovation.

We help insurance providers optimize claims processing, member engagement, and risk management with AI-driven analytics, automation, and cloud-based solutions.

Our digital healthcare solutions enhance patient care, revenue cycle management, and EHR/EMR interoperability, enabling seamless, data-driven healthcare delivery.

We collaborate with ISVs to develop innovative healthcare software, ensuring seamless integration, scalability, and compliance with industry standards.
We empower medical device manufacturers with smart automation, regulatory compliance solutions, and AI-driven insights to enhance product innovation and supply chain efficiency.
Our centralized system of records enables seamless data management, serving as a single source of truth for healthcare providers, payers, and life sciences organizations. We address key industry challenges by offering solutions that

Personalized healthcare experiences driven by AI and automation.

Meeting HIPAA, GDPR, and evolving global healthcare regulations.

Maximizing ROI through seamless digital experiences.

Secure, real-time data exchange between healthcare providers.

Ensuring resilience in healthcare operations.

Scalable, compliant digital ecosystems for better outcomes.
Our tailored solutions help healthcare organizations modernize, innovate, and scale while staying compliant and competitive.
Aligning digital solutions with business objectives.
Ensuring compliance with industry standards.
Leveraging data for improved patient outcomes.
Expanding care beyond hospital walls.
Enabling early disease detection and data-driven care.
Upgrading legacy systems for seamless interoperability.
Connecting EHR/EMR, cloud, and IoT ecosystems.
Safeguarding patient data with robust security measures.